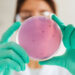
La Comisión y la OMS mejoran la respuesta a la resistencia a los antimicrobianos

La Comisión Europea ha anunciado este martes un refuerzo en los controles sobre los productos importados a la Unión Europea, incluyendo alimentos, productos animales y vegetales. Las nuevas medidas contemplan un aumento del 50% en las auditorías realizadas en países fuera de la UE durante los próximos dos años, así como un incremento del 33% en las auditorías efectuadas en los puestos de control fronterizos de la UE, además de un seguimiento más estricto de los productos y países que no cumplen con las normativas establecidas.
Bruselas presentó este martes, 9 de diciembre, un paquete de medidas destinado a fortalecer los controles sobre los productos importados a la Unión Europea, con el fin de asegurar que los alimentos, productos animales y vegetales que ingresan al territorio europeo cumplan con los estrictos requisitos de seguridad alimentaria y sanidad fitosanitaria establecidos por la Unión.
El comisario de Salud y Bienestar Animal, Olivér Várhelyi, indicó que la seguridad alimentaria es una prioridad para el Ejecutivo comunitario, no solo para los productos producidos dentro de la UE, sino también para aquellos provenientes de fuera del bloque.
Várhelyi subrayó que, como uno de los mayores mercados de alimentos a nivel mundial, la UE debe asegurar que todos los productos importados cumplan con sus rigurosas normas de salud y seguridad. Según el comisario, estas nuevas medidas reforzarán el sistema de controles oficiales, contribuyendo a la protección de los ciudadanos, los agricultores y las empresas de la UE.
El Ejecutivo comunitarió anunció un aumento en la realización de auditorías en países no pertenecientes a la Unión Europea, con el objetivo de garantizar que las inspecciones y controles en esos países estén alineados con las normativas europeas. Se prevé que el número de auditorías en terceros países se incremente en un 50% durante los próximos dos años.
En los controles dentro de la Unión, las auditorías realizadas en los puestos de control fronterizos europeos se incrementarán en un 33% para verificar que los Estados miembros estén cumpliendo con los estándares establecidos en la legislación comunitaria.
La Comisión también destacó que implementará un sistema de seguimiento más riguroso de los productos y países que no cumplan con las normas sanitarias y fitosanitarias. En estos casos, se aumentará la frecuencia de los controles cuando sea necesario, con el fin de identificar productos que no cumplan con las exigencias de la UE.
Asimismo, se brindará apoyo a los Estados miembros para llevar a cabo estos controles adicionales, proporcionando recursos y asistencia técnica para mejorar la capacidad de inspección en las fronteras.
De manera paralela, se creará un grupo de trabajo específico para mejorar los controles de importación, con el objetivo de ofrecer formación a los funcionarios nacionales y actualizar las normativas relacionadas con productos que contengan trazas de pesticidas peligrosos. El Ejecutivo comunitario explicó que estas acciones tienen como finalidad fortalecer el sistema de seguridad alimentaria de la UE, protegiendo tanto a los consumidores como al medio ambiente.
Adicionalmente, se lanzará un programa de formación dirigido a unos 500 funcionarios de las autoridades nacionales para fortalecer su capacidad para realizar controles oficiales. La Comisión también actualizará las normativas en relación con la importación de productos que contengan trazas de pesticidas especialmente peligrosos, alineándolas con las normativas internacionales más recientes.